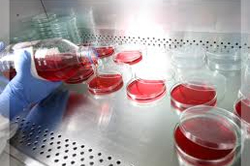

Premian trayectoria de Grupo Carval de Colombia
Thursday 24 October, 2013
El fundador del colombiano grupo Carval, Carlos Vallecilla Borrero, recibió el premio Emprendedor del Año Master 2013, de la firma Ernst & Young Colombia.
Grupo Carval se dedica a la producción y venta de farmacéuticos para la industria pecuaria.
La empresa ahora tiene presencia en 17 países del continente, y se encuentra evaluando la posibilidad de entrar a Africa y Europa.
Fuente: Portafolio
